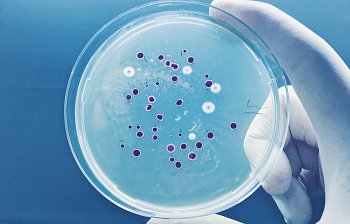

Project Plus Unit 8 A
ALL LEVELS
Vydáno dne 03.10.2005
The Red Planet
bacteria
- bakterie
BrE
/
bək'ti:rɪə/
AmE
/
bək'ti:rɪə/
noun
-
very small organisms that you can only see through a microscope
bone
- kost
noun
-
one of the hard parts inside your body
bring
- přinést, přivést, přivézt, vzít (s sebou)
verb
-
to come somewhere with something or with somebody, to take something or somebody with you
broadcast
- vysílat
BrE
/
'brɔ:dkɑ:st/
AmE
/
'brɔ:dkæst/
verb
-
to send radio or TV waves through the air
comet
- kometa
BrE
/
'kɒmɪt/
AmE
/
'kɑ:mɪt/
noun
-
a bright thing in the sky that has a light head and a long tail
fossil
- zkamenělina, fosílie
noun
-
a part of a living organism or the shape of its body preserved in rock for a very long time
gravity
- gravitace, přitažlivost
BrE
/
'grævɪti/
AmE
/
'grævət̬i/
noun
-
a natural force that attracts things
invader
- útočník, vetřelec
BrE
/
ɪn'veɪdə/
AmE
/
ɪn'veɪdər/
noun
-
a person or country who attacks a country and takes control of it by force
meteorite
- meteorit
BrE
/
'mi:tɪəraɪt/
AmE
/
'mi:t̬iəraɪt/
noun
-
a piece of rock from space that has fallen onto the Earth
pull
- tahat, táhnout, zatáhnout
verb
-
to move something towards you; to draw something along behind you
space probe
- vesmírná sonda
BrE
/
'speɪsˌprəʊb/
AmE
/
'speɪsˌproʊb/
noun
-
a kind of spacecraft with no people in it that is sent through space to gather information and send it back to earth
spaceship
- vesmírná loď, kosmická loď
BrE
/
'speɪsˌʃɪp/
AmE
/
'speɪsˌʃɪp/
noun
-
a vehicle used for travelling between planets or stars, it usually appears in sci-fi
universe
- vesmír
BrE
/
'ju:nɪvɜ:s/
AmE
/
'ju:nɪvɜ:rs/
noun
-
all space and everything that exists in it, including all the stars, planets, and galaxies

Project Plus Unit 8 A
Project Plus Unit 8 A
